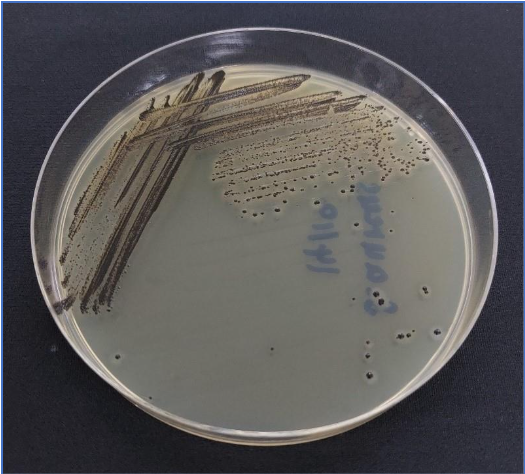
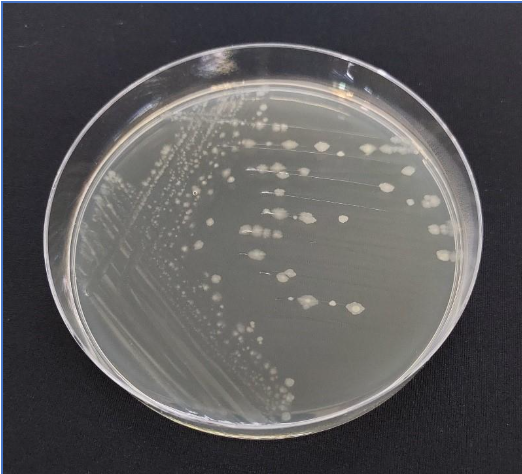
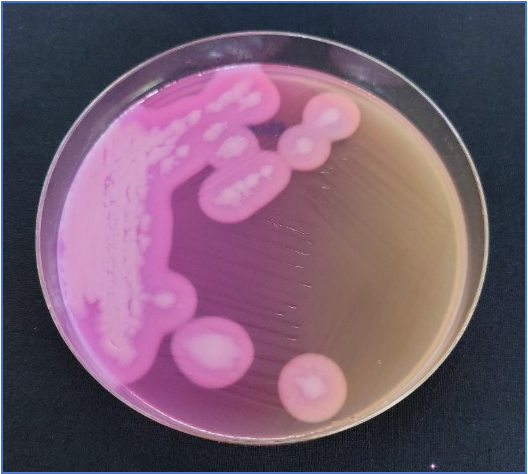

การทดสอบหาเชื้อจุลินทรีย์ที่ทำให้เกิดโรค ของภาชนะบรรจุที่ทำจากพลาสติก
ตามประกาศกระทรวงสาธารณสุขเรื่อง กำหนดคุณภาพหรือมาตรฐานของภาชนะบรรจุที่ทำจากพลาสติก ฉบับที่ ๔๓๕ พ.ศ. ๒๕๖๕ ข้อ ๔ (๒) จุลินทรีย์ที่ทำให้เกิดโรค (Notification of the Ministry of Public Health (No. 435) B.E. 2565 (2022) Pathogenic Microorganisms)



ตามประกาศสำนักงานคณะกรรมการอาหารและยา เรื่อง คำชี้แจงประกาศกระทรวงสาธารณสุข ฉบับที่ ๔๓๕ พ.ศ. ๒๕๖๕ แนะนำการตรวจไว้ 4 ชนิด ดังนี้
1. Staphylococcus aureus (S. aureus)
2. Clostridium perfringens (C. perfringens)
3. Bacillus cereus (B. cereus)
4. Salmonella spp.

ซ้าย: เชื้อ S. aureus เจริญบนอาหาร Baird parker agar (BPA)
ขวา: เชื้อ C. perfringens เจริญบนอาหาร Tryptose-sulfite-cycloserine (TSC) agar

ซ้าย: เชื้อ B. cereus เจริญบนอาหาร Mannitol Egg yolk Polymyxin (MYP) agar
ขวา: เชื้อ Salmonella spp. เจริญบนอาหาร Xylose Lysine Deoxycholate agar (XLD) agar
Leave a reply
